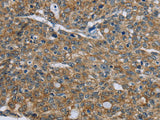
CK-5 Polyclonal Antibody

CK-5 Polyclonal Antibody
SKU: E-AB-10147-200
CK-18 Polyclonal Antibody Host Rabbit
| SKU # | E-AB-10147 |
| Reactivity | Human, Mouse, Rat |
| Host | Rabbit |
| Applications | IHC |
Product Details
| Isotype | IgG |
| Host | Rabbit |
| Reactivity | Human, Mouse, Rat |
| Applications | IHC |
| Clonality | Polyclonal |
| Immunogen | Recombinant protein of human KRT5 |
| Abbre | CK-5 |
| Synonyms | 58 kDa cytokeratin, CK-5, CK5, Cytokeratin-5, Cytokeratin5, DDD, DDD1, Dowling-Meara/Kobner/Weber-Cockayne types), EBS2, K2C5, K5, Keratin, Keratin 5, epidermolysis bullosa simplex 2 Dowling-Meara/Kobner/Weber-Cockayne types, ke, keratin 5 (epidermolysis bullosa simplex |
| Swissprot | |
| Cellular Localization | Cytoplasm |
| Concentration | 0.4 mg/mL |
| Buffer | Phosphate buffered solution, pH 7.4, containing 0.05% stabilizer and 50% glycerol. |
| Purification Method | Affinity purification |
| Research Areas | Cancer, Signal Transduction |
| Conjugation | Unconjugated |
| Storage | Store at -20°C Valid for 12 months. Avoid freeze / thaw cycles. |
| Shipping | The product is shipped with ice pack,upon receipt,store it immediately at the temperature recommended. |
Related Reagents
| Applications | Recommended Dilution |
| IHC | 1:50-1:200 |
Background
The protein encoded by this gene is a member of the keratin gene family. The type II cytokeratins consist of basic or neutral proteins which are arranged in pairs of heterotypic keratin chains coexpressed during differentiation of simple and stratified epithelial tissues. This type II cytokeratin is specifically expressed in the basal layer of the epidermis with family member KRT14. Mutations in these genes have been associated with a complex of diseases termed epidermolysis bullosa simplex. The type II cytokeratins are clustered in a region of chromosome 12q12-q13.